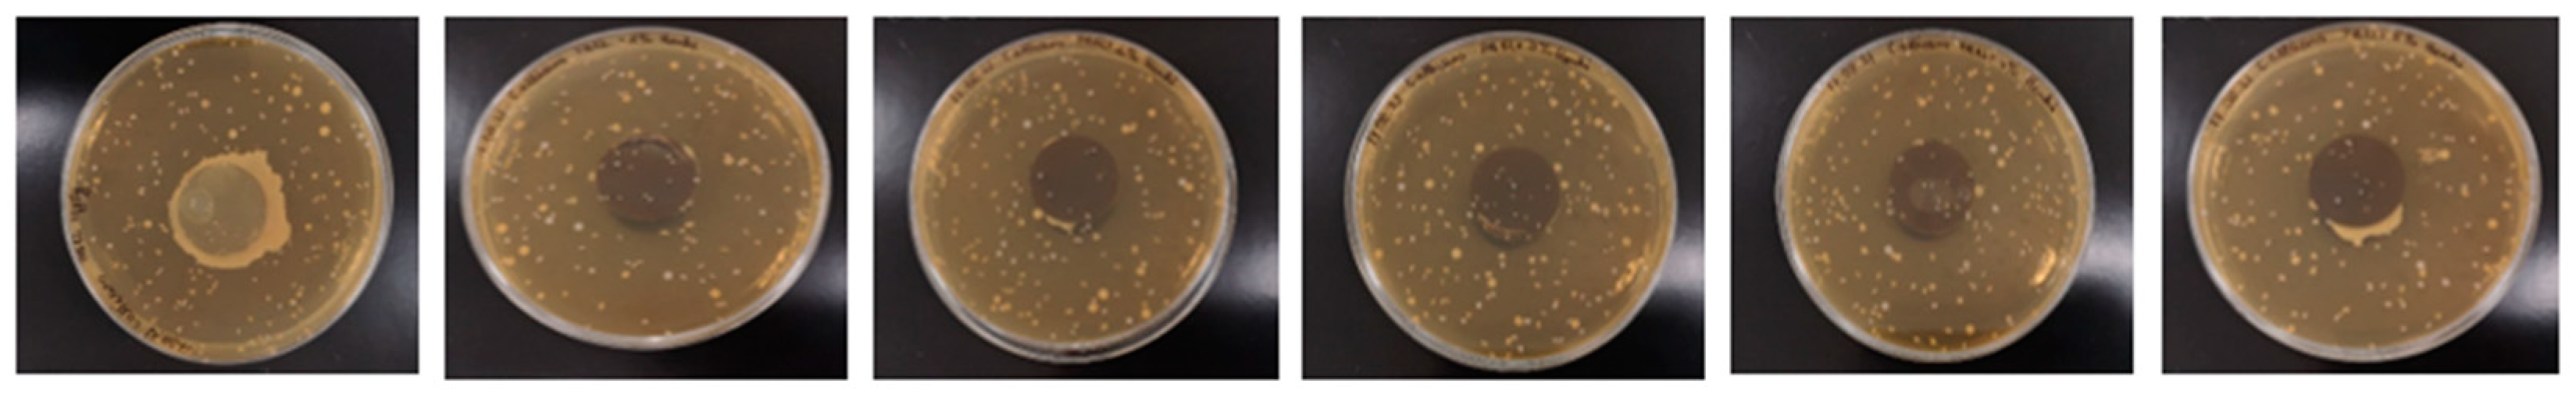
Polymers 14 03025 g0a4 550

1. Introduction
Polymer and polymer-based composites have gained tremendous popularity as materials for the production of everyday appliances such as computers, pens, cases, packaging, toys, etc., due to their low price, good mechanical properties, high corrosion resistance, and easy shaping. However, one of their main drawbacks is the lack of any resistance to microorganisms. With their popularity in our everyday lives and presence in public spaces, pathogens such as fungi, viruses, and bacteria can settle on their surfaces and be spread rapidly by people. Obviously, the pathogens transmission will be dependent on the survivability of the pathogens on the surface. The longer they live, the higher risk that pathogens will be transmitted. It was examined that the virus of SARS-CoV-2 remained much longer (8 h) on a plastic surface compared to the other surfaces such as aluminum, copper, steel, rubber, cloth materials, and paper [
1]. Moreover, a whole range of factors such as humidity, temperature, dust, sweat, dead skin cells or food particles contribute to rapid multiplication of pathogens. It is known that pathogens are mainly present in hospitals, and are responsible for numerous infections because they remain on plastic objects such as bedside rails, tables, floors. Besides, thermoplastic polymers are used to produce various types of small medical devices such as syringes, catheters, urine collectors, volumetric infusion pumps, packages as well as personal protective equipment including masks, gloves, and disposable aprons [
2,
3]. For instance, the Methicillin-Resistant
Staphylococcus aureus (MRSA), and
Vancomycin-Resistant Enterococci (VRE) were collected from 59% and 46% of the rooms in hospitals, respectively. Their presence was associated with insufficient surface cleaning and nurse understaffing. Moreover, the research shows that urinary catheters are responsible for more than 80% of infections of the urinary tracts [
4,
5]. Such a situation has prompted scientists to research the effectiveness of increasing the antimicrobial activity of the polymers and looking for new agents to combat pathogenic organisms.
The methods of creating polymeric materials which inhibit or kill microorganism are constantly being sought. These materials can be produced by a direct mixing of the biocide agent with the polymer during processing (e.g., extrusion) or by applying a coating on the surface of the protected object. The metal particles such as silver and copper are the most commonly used additives. Silver shows high antimicrobial activity, and it is widely used in the packaging industry since it improves the shelf life of food [
6]. However, some research confirms that silver ions and silver nanoparticles kill bacteria, human mesenchymal stem cells, and peripheral blood mononuclear cells at the same concentration. Due to the release of ions, silver ions can interact with cell wall components, nucleic acids, or metabolic enzymes. However, some other papers show that the antimicrobial mechanism is based on not direct but indirect damage caused by reactive oxygen species and the subsequent oxidative stress [
7,
8]. It is important to highlight that other metal particles such as copper possess a lower price and high antimicrobial properties against many types of bacteria, and therefore it is used as a water purifier, antibacterial and antifouling agent. To avoid working with expensive metal particles, metal oxides (e.g., CuO) are commonly used instead of silver salts such as silver nitride and silver acetate. In the group of metal oxides, titanium dioxide (TiO
2) and zinc oxide (ZnO) have been tested as a filler in the polymers to obtain the biocide material. The first one has odor inhibition, a self-cleaning mechanism and low price [
9], while ZnO enhances reactive oxygen species responsible for the bacterial inhibition mechanism [
10]. It has been tested as an effective biocidal material for the protection of old paper documents [
11]. From the other group of biocidal additives, aluminum (Al), iron oxide (FeO), magnesium oxide (MgO), calcium oxide (CaO), carbon nanotubes (CNTs), and even montmorillonite have been used as fillers in the different thermoplastic polymers. The examples of biocidal composites based on thermoplastic polymers are included in
Table 1. As it can be seen from the collected data, metal-based additives are still primarily used as biocidal materials.
It should be noted that the antimicrobial activity of the metals and their oxides is not always as good as desired. The biocide composites are often resistant to only some and not all strains of bacteria, fungi, or viruses. It is so due to the too long production–consumption cycle of particles, which lowers their efficiency and relatively small surface area [
12]. Hence, to improve the biocidal properties of the metals and their oxides, it has been started to synthesize them with the nanoscale using the established processes in the recently developed nanotechnology science. As a result, the nanoparticles having new physicochemical properties are formed. Compared to microparticles, their surface-area-to-volume ratio is much higher, affecting the significant increase in biological activity. Because of the higher activity of the nanoparticles themselves and resulting faster dissolving in a solution, more metal ions are formed that interact with the pathogens [
2].
Many different approaches have been tested to incorporate the biocide nanoparticles in the polymers, and they are mainly dependent on the final applications of the material (nanocomposite) as well as the possibilities and limitations of the method. For instance, the biocidal polymeric fibers can be produced by immersing the pure fibers in the nanoparticles solution or through the melt-spinning process, which does not require using any solvent. The main drawback of the nanoparticles is their tendency to form agglomerates, the presence of which may reduce the final properties of the material. Therefore, they should be destroyed during manufacturing to obtain the homogenous dispersion and distribution of the nanoparticles in the whole polymer matrix. The twin-screw extrusion (melt-blending) is often applied for the mixing of thermoplastics with nanoparticles, since the applied shear rate causes agglomerates destroying, resulting in homogenous dispersion of the nanoparticles [
13]. The biocidal nanocomposites in the form of pellets or powder can be further applied in the processes such as injection molding (containers, syringes), melt-spinning (fibers, yarns), single-screw extrusion (filaments for 3D printing), or melt-blown (masks, filters).
Table 1.
The examples of antimicrobial thermoplastic composites described in the literature.
Table 1.
The examples of antimicrobial thermoplastic composites described in the literature.
| Polymer Matrix | Filler Type and Concentration | Pathogen | Activity | Ref. |
|---|
| PA12 | 2 wt % PHMG-DBS | Trychophyton mentagrophytes | qualitative activity | [14] |
| PA12 | 2–3 wt % silver nanopowder | Escherichia. coli
Staphylococcus aureus | qualitative activity | [15] |
| PA12 | 4 wt % cuprous oxide-Cu2O | E. coli
S. aureus | qualitative activity | [16] |
| PA11 | 5 wt % PHMG-DBS | E. coli
Bacillus subtilis | >99.9% | [17] |
| PA11 | 10 wt % Cu | E. coli | >99.9% | [18] |
| PLA | 1–5 wt % montmorillonite | S. aureus
Enterococcus. faecalis
E. coli | lack of activity | [19] |
| PLA | 8 wt % TiO2 | Aspergillus fumigatus
E. coli | >94% | [17] |
| PANI | 1 wt % and 3 wt % AgNO3 | S. aureus | over 99% | [20] |
| PP | TiO2 coated
with 1 wt % of nano-Ag | S. aureus | over 99% | [3] |
| PP | 5 wt % TiO2-nanotubes | E. coli | 17% | [21] |
| LDPE | 10 wt % Organo Modificated CaO | E. coli | 99.9% | [22] |
| PAN | 3 wt % AgNO3/3 wt %TiO2 | S. aureus | over 99% | [23] |
As confirmed in much research, nanoparticles are responsible for the antimicrobial properties in the polymer/metal nanocomposites. However, their effectiveness is dependent on the number of metal ions formed in the presence of water. According to the mechanism described by Palza for the bacteria [
2], water molecules coming from the bacteria medium diffuse into the surface of the nanoparticles. Then, water and dissolved oxygen cause the dissolution or corrosion processes when they reach the nanoparticles’ surface, leading to the formation of the ions. Moving metal ions reach the composite surface, damage the bacteria membrane and diffuse into the pathogen.
It should be noted that the biocidal properties of the polymer nanocomposites are dependent on the type of polymer used, especially its polarity and crystallinity. The highest number of metal ions is formed in more polar (hydrophilic) polymer matrices having lower crystallinity. It is associated with the ease of water absorption and movement of the macromolecules chains, which do not prevent reaching the surface of the water molecules [
24].
This paper presents the characterization of the polymer/metal nanocomposites based on PA12 and the mixture of the nanoparticles of metal oxides-CuO, ZnO, and TiO
2 obtained by the melt-blending process. Such composites containing different types of metal oxides have not yet been described in the literature, which emphasizes the high novelty of the conducted research. It was examined how much the metal oxides affect the rheological and thermal properties of PA12, and the results were related to the polymer wettability and dispersion of the nanoparticles. The biological tests included the activity against representative bacteria (
Escherichia coli), fungi (
Candida albicans), and viruses (
Herpes simplex virus type 1 and
Adenovirus 5). Additionally, in vitro cytotoxicity of the nanocomposites and the programmed cell death were assessed. Because most of the polymer/metal nanocomposites described in the literature are tested against only one type of pathogens (see
Table 1), the presented research is valuable for current challenges with the high activity of the microorganisms.
2. Materials and Methods
2.1. PA12 Composites Preparation
As a polymer matrix, PA12 was supplied in pellet form from the Evonik company (Essen, Germany), with the trade name Vestamid Z7321. It has the density of 1.01 g/cm3, water absorption of 1.5%, a melting point of 179 °C, and a processing temperature between 190 and 240 °C. The pellets of PA12 were initially dried in a vacuum oven at 90 °C for at least 24 h before further usage. As an antimicrobial filler, a mixture of CuO, ZnO, and TiO2 powders with the trade name ACRAZ-172T was used as a filler. It is in the form of a light black powder. The average grain size of these oxides was between 300 and 1000 nm, a melting point of 962 °C, and a boiling point of 2200 °C. Three oxides were intentionally applied as a filler to PA12 to strengthen antimicrobial activity of the composite. Copper oxide shows high antimicrobial activity at its surface. Zinc oxide is much less toxic, but when in contact with copper oxide, the system shows much stronger activity. Titania is added to the composite to increase wettability of the surface, which is necessary for proper and high activity of CuO and ZnO.
As presented in
Figure 1, PA12 composites were produced by mixing the polymer pellets and the oxides powder using a laboratory twin-screw extruder HAAKE MiniLab (ThermoFisher Scientific, Waltham, MA, USA) equipped with a bypass cycle. The concentration of the metal oxides was 1, 2, 3, 4, and 5 wt %. The composites were extruded at 190 °C, with the rotations of the screws of 100 rpm and a mixing time (residence time) of 5 min. The fabricated pellets were afterwards processed into the round specimens with 25 mm diameter and 0.1 mm thickness using a HAAKE Mini Jet Piston Injection Molding System (ThermoFisher Scientific, Waltham, MA, USA). The parameters of the injection molding were as follows: 220 °C—the temperature of the barrel, 50 °C—the mould temperature, 700 bars and 10 s injection pressure and time, and 600 bars and 8 s—the post-processing injection pressure and time. The produced rounds were used in the rheological and antimicrobial tests as well as for the microstructure observations. Using a computer microtomography, it was also determined that the pores content in the composites was lower than 2%.
2.2. The Analysis of the Physicochemical Properties
The wettability of the metal oxides by PA12 pellet grains was analyzed using a Drop Shape Analyser apparatus DSA100M(Kruss GmbH, Hamburg, Germany) equipped with a high-temperature cell and a digital camera (20 frames per second). The temperature cell enables the heating of samples in the range from 0 to 400 °C and controls the temperature inside the cell with the accuracy of 0.1 °C. Wetting angles were measured by tangents fit. In order to perform the measurement, the PA12 pellet grain was placed on the surface of the oxides powder filler in the center of the cell under room temperature conditions. Then, the heating of the cell was started at a rate of about 10 °C per minute. Thanks to the continuous video observation during the experiment, changes in the texture of the pellet matrix during its melting and interaction with the metal oxides were observed. The first melting effects of the PA12 pellet, the first contact angle of the molten pellet and contact angles for its full possible spread were also noticed.
The surface composition and electronic states of the elements at the surface of the filler patty before and after contact with melted PA12 were analyzed with X-ray photoelectron spectroscopy (XPS). The EA-15 (PREVAC, Rogów, Poland) hemispherical analyzer equipped with dual anode X-ray source RS 40B1 (PREVAC, Rogów, Poland) was used for the surface analysis. The spectrometer was calibrated with Ag, Au and Cu foils according to the ISO 15472:2010 standard. The area of analysis was approximately 2 mm2 and the depth of analysis was about 10 nm.
The measuring of the quality of the composites and dispersion of the oxides in the PA12 matrix was carried out using a scanning electron microscope (SEM HITACHI TM3000, Tokyo Japan). The samples for the test were prepared by freezing the specimens after injection molding in liquid nitrogen for 10 min and then breaking them. The samples were stuck to the metal measuring tables using double-sided carbon tape so that the fractures faced upwards. The surfaces of the samples were coated with a conductive layer using an electro-deposition method to make them electrically conductive. The microstructure images were collected at magnifications of ×500, ×1000, ×1500, and ×2000. The quantitative analysis of the oxide dispersion was performed using the ImageJ software (Version: 2.0.0, National Institutes of Health and the Laboratory for Optical and Computational Instrumentation, Madison, WI, USA), which allows to count the diameters of agglomerates. For each composition, a minimum of seven images was taken for the calculation. The obtained results were shown in the form of histograms.
Thermogravimetric analysis (TGA) was performed to analyze the thermal stability of the composites. This analysis was carried out using a TGA Q500 (TA Instruments, New Castle, DE, USA) for the samples weighing 10 ± 0.5 mg placed in platinum pans. The samples were heated from 0 to 820 °C in a nitrogen atmosphere with a heating rate of 10 °C/min and a flow rate of 10 mL/min in a chamber and 90 mL/min in an oven. From the obtained curves, the degradation temperature at 5% (T5%) and 10% (T10%) weight loss, and the temperature of the maximum weight loss rate (Td), were determined.
The effect of the addition of the metal oxides on the thermal properties of PA12 was studied using a Q1000 Differential Scanning Calorimeter (TA Instruments, New Castle, DE, USA). The samples weighing 6.5 ± 0.2 mg were placed in an aluminum hermetic pan. The used program included first heating from −80 °C to 240 °C, then cooling from 240 °C to −80 °C and second heating from −80 °C to 240 °C with a scan rate of 10 °C/min at nitrogen atmosphere. Using the Universal V4.5A TA software, the characteristic temperatures such as melting point (
Tm) and crystallization temperature (
Tc) were determined. The crystallinity content (
Xc) of the PA12 composites were calculated from the following equation number 1:
where:
ΔHc is the enthalpy of melting taken as the area under the melting peak from the second heating curve,
Δ
is the melting enthalpy of 100% crystalline PA12, which is 209 J/g [
25]
x is the weight fraction of metal oxides.
The processability of the PA12/oxides composites was investigated in terms of their rheological properties such as complex viscosity, storage, and loss modulus. The round specimens having a diameter of 1.5 mm and a thickness of 2 mm (
Figure 1) were tested using an oscillatory ARES 4400-0107 rheometer (Rheometric Scientific Inc., TA Instruments, New Castle, DE, USA) in a parallel plate geometry mode. Firstly, the amplitude sweep test as a function of the variable strain γ (0.07–100%) at a constant frequency of 1 Hz was performed. From the linear elastic range of the storage modulus curves, the strain of 10% was selected. With that strain, a dynamic oscillatory stress-controlled rotational test was performed at 190 °C with a frequency sweep from 0.1 to 100 Hz.
2.3. Biological Tests
The prepared composites in the form of the round specimens were analyzed against representative bacteria, fungi, and viruses using the round from the injection molding machine (see
Figure 1). The antibacterial activity of samples against
E. coli was determined using two methods. The qualitative determination was made based on the modified protocol of ISO 20645 and the quantitative determination was based on the AATCC Test Method 100 protocol with modification. In the ISO 20645 method, the samples were placed between two agar layers and the plates were kept for incubation at 37 °C for 24 h. The lower layer contained 10 mL of Luria broth (LB) and the upper layer had 5 mL of LB with 5 × 10
5 cells/mL of the bacteria. The bacteria came from a previous LB inoculum incubated for 24 h at 37 °C. At the end of incubation, the zone of inhibition formed around the round specimen was measured in millimeters and recorded. In the AATCC Test Method 100, the tested microorganisms were grown in LB at 37 °C for 24 h, and then they were suspended in appropriate media and the cell densities were adjusted to 0.5 McFarland standards at 630 nm wavelength using a spectrophotometric method (1–1.5 × 10
8 cells/mL). The samples were then inoculated with 5 mL microbial suspension and incubated for 24 h. After that contact period, 45 mL of neutralizing solution (phosphate-buffered saline PBS, pH = 7.4) was added to the falcon tubes containing the inoculated treated swatches. After 1 min of shaking, standard serial dilution was performed and 10 μL of each solution were cultured on LB plates and incubated for 24 h at 37 °C. The reduction of microbes was calculated by the following equation: [(no. bacteria on pure PA12—no. bacteria on PA12 with oxides)/no. bacteria on pure PA12] × 100.
Antifungal activity of PA12 was assessed using the following quantitative methods: AATCC TM100-2019 (The American Association of Textile Chemists and Colorists, AATCC TM100-2019, “Test Method for Antibacterial Finishes on Textile Materials: assessment of” and PN-EN ISO 20743:2013-10E “Textiles—Determination of Antibacterial Activity of Textile Products”). Briefly, C. albicans ref. strain 90028 ATCC (LGC Standard, Poland) at 5 × 103 to 6 × 105 CFU/mL of YEPD was incubated with swatches at 35 °C for 24 h. Then, tenfold dilutions were plated on YEPD agar and the number of CFU was counted for tested and control (without metal oxides) swatches. Additionally, anti-C. albicans 90028 activity was performed using the qualitative method AATCC TM90-2011 (2016)e (The American Association of Textile Chemists and Colorists, AATCC TM90-2011(2016)e, “Test Method for Antibacterial Activity of Textile Materials: Agar Plate”). Briefly, the tested and control swatches were put on top of the solid agar inoculated with blastoconidia (2.6 × 103 CFU/mL) and incubated at 35 °C for 24 h. Zones of inhibition and growth under the tested swatches were compared to the control ones. R% was calculated using Equation: (A − B)A × 100% = %R, where A means CFU recovered from the PA12 control inoculated with C. albicans and incubated over the 24 h contact period; B means CFU recovered from the PA12 with metal oxide inoculated and incubated over the 24 h contact period.
Virucidal properties were determined using Herpes simplex virus type 1 (HSV-1-ATCC
® VR-1493™) and human
Adenovirus 5 (Ad-5 virus—strain Adenoid 75, ATCC VR-5
TM). Two types of cell lines obtained from American Type Culture Collection—ATCC (Rockville, MD, USA) (A549-human lung carcinoma (ATCC, No. CCL-185
TM) and HeLa -human cervix carcinoma (ATCC, No. CCL-2
TM)) were used in this experiment. Dulbecco’s Modified Eagle’s Medium—DMEM (Lonza, Basel, Switzerland) served as substrate. Media were supplemented with 10% fetal bovine serum (FBS) and 4 mM L-glutamine (Biological Industries, Kibbutz Beit-Haemek, Israel), 100 U/mL of penicillin and 100 g/mL of streptomycin (Sigma-Aldrich, Munich, Germany). The substances were tested using International Standard ISO 21702 (Measurement of antiviral activity on plastics and other non-porous surfaces, Geneva, Switzerland, 2019). This document specifies proper methods for measuring antiviral activity on plastics and other non-porous surfaces of antiviral-treated products against specified viruses. According to the standard (ISO 4.1), alternative viruses to influenza virus and feline calicivirus may be used. Therefore, the study was conducted using
Adenovirus 5 commonly found in humans. This pathogen represents non-enveloped viruses, belonging to the group of most difficult to inactivate viruses. The virus included in the test is responsible for colds. The second study was conducted using human herpesvirus type 1. This pathogen represents enveloped viruses. The virus included in the test is responsible for herpes in human. In the laboratory, these strains reach high titers, so it was possible to validate the method quickly. The virucidal efficacy was tested according to ISO 21702:2019 (ISO 7. 1-7. 4). For this purpose, a sample of the test material (ISO 4. 3. 16) treated with SCDLP neutralizer was placed in a sterile petri dish. On the sample prepared in this way, 400 µL of the test virus were spotted and covered with a 2 × 3 cm layer of polymer. The sample was incubated at 25 °C for 24 h at 90% humidity. After this time, the virus was collected by pipette. The study was conducted in 3 replicates. In parallel, the whole procedure was repeated using a control specimen (pure PA12) as a non-virulent material. In addition, immediately after virus inoculation onto the control round specimen, virus titers were tested (3 replicates). According to ISO 21702:2019, which allows to use the TCID
50 method instead of the plaque test, serial dilutions up to 10
−8 of the viruses collected from each disc were prepared. In eight repeats, 50 µL of each dilution were added to the microtiter plate containing a monolayer of confluent A549 or HeLa cells. The plates were observed daily for up to 4 days for the development of viral cytopathic effect, using an inverted microscope (Olympus Corp., Hamburg, Germany; Axio Observer, Carl Zeiss MicroImaging GmbH). The calculation of the infective dose TCID
50/mL was conducted using the Spearman and Karber method with the following formula:
where:
x0 is log10 of the lowest dilution with 100% positive reaction,
r is the number of positive determinations of lowest dilution step with 100%,
positive and all higher positive dilution steps,
n is the number of determinations for each dilution step.
The programmed death of the L929 ATCC cell line (LGC, Standard, Poland) treated with PA12/metal oxides composites was assessed using flow cytometer BD FACS Lyrics 2L6C with FAC Suite Software 1.4 RUO (BD Biosciences, Mississauga, ON, Canada). Liquid extracts of PA12 containing 3 wt % and 4 wt % oxides were prepared in DMEM (ATCC, LGC Standard, Poland) after 4 h and 24 h extraction according to ISO 10993-5:2009 (E). The monolayer of cells (1 × 10
4 cells/mL) was treated with the extracts for 18 h. Then, the treated cells were stained with annexin V and propidium iodide (FITC Annexin V Apoptosis Detection Kit I BD Biosciences, Franklin Lakes, NY, USA) [
26]. Briefly, L929 were seeded in 24-well plates (10,000 cells/mL) and incubated for 24 h. Then, the medium was replaced with 100 μL of extracts (10% or 100%). The plates were incubated for 24 h at 37 ± 1 °C with 5% CO
2. Simultaneously, to assess in vitro cytotoxicity (ISO 10993-5:2009E) of PA12 containing 3 wt %, 4 wt % and 5 wt % oxides, L929 (8000 cells/100 µL) were seeded in the 96-well plates. After treatment, 11 µL PrestoBlue reagent (ThermoFisher Scientific, Waltham, MA, USA) was directly put into each well and incubated for 1.5 h. The absorbance was recorded at 570 nm (and reference at 600 nm) with Infinite M200 reader (Tecan, Durham, NC, USA). The GraphPad Prism 8.4.3 (GraphPad Software Inc., La Jolla, CA, USA) was used for the data analysis. Differences between the groups were tested using Bonferroni’s test multiple comparison tests. Differences were considered statistically significant at
p < 0.05.
4. Conclusions
This paper describes the thermoplastic composites of PA12 mixed with 1–5 wt % of metal oxides (CuO, ZnO, and TiO2) fabricated by the melt-blending method. To obtain as high as possible biocidal activity, the used oxides occur in the nanosize, but after the extrusion process they tend to agglomerate. Therefore, SEM images show homogenously dispersed oxides in the PA12 matrix but in the form of the agglomerates. Their diameter decreases with oxides concentration, which is associated with the increased shear stress caused by higher viscosity. This growth in the viscosity of the composites was measured by rotational rheology and was the highest for 5 wt % of the oxides which were characterized by the lowest agglomerates diameter of 4.29 ± 1.69 µm. Due to the presence of the agglomerates, the interactions between polyamide macromolecules and oxides are not sufficient to affect the viscoelastic properties of PA12 since storage and loss modulus remain almost unchanged for the composites. What is more, the loss modulus is larger than the storage modulus and it leads to the conclusion that the composites of PA12 and metal oxides will behave more like viscous rather than elastic liquids. Such a property is positive from applying these polymeric composites in the standard processing methods use for the thermoplastic polymers. What is more, there are only slight changes in the temperatures and crystallinity behavior in the presence of metal oxides. It was confirmed that metal oxides are well-wetted by PA12, and the composites became less hydrophilic in the presence of hydrophobic oxides. Surface studies indicate interaction of the PA12 amide groups with metal cations resulting in the reduction of the copper surface, selective bonding with zinc, and bonding to amide groups for titania. At 4 wt % of the oxides, the contact angle was the lowest (80°). At the same time for this composite, the highest biocidal activity against the representatives of bacteria, fungi, and viruses was reported. As the effect of 4 wt % oxides, the quantitative antimicrobial activity depicts the reduction of the E. coli by 87%, C. albicans by 53%, and virus Herpes simplex 1 by 90%. Flow cytometry also proved that cell viability remained at 71.16–72.75% in the presence of PA12 + 4 wt % oxides and that composites are not toxic for the fibroblasts. Studying the reported toxicity of the commonly used silver particles, the mixture of metal oxides seems to be a promising and safe substitute. It needs to be highlighted that PA12 composites demonstrate high biocidal activities and desired physicochemical properties. At the same time, these composites can be processed into the final products such as injected molded parts for the hospitals and nonwovens used as filters or filaments for 3D printing.
To sum up, the main achievements were highlighted below:
PA12 composites containing CuO, TiO2 and ZnO prepared by melt-blending
Obtaining the biocidal activity against E. coli, C. albicans and Herpes simplex 1
The lack of toxicity of the composites for the human cells
Founding the highest activity and the lowest contact angle at 4 wt % oxides
A slight effect of the oxides on the viscoelastic properties and thermal stability